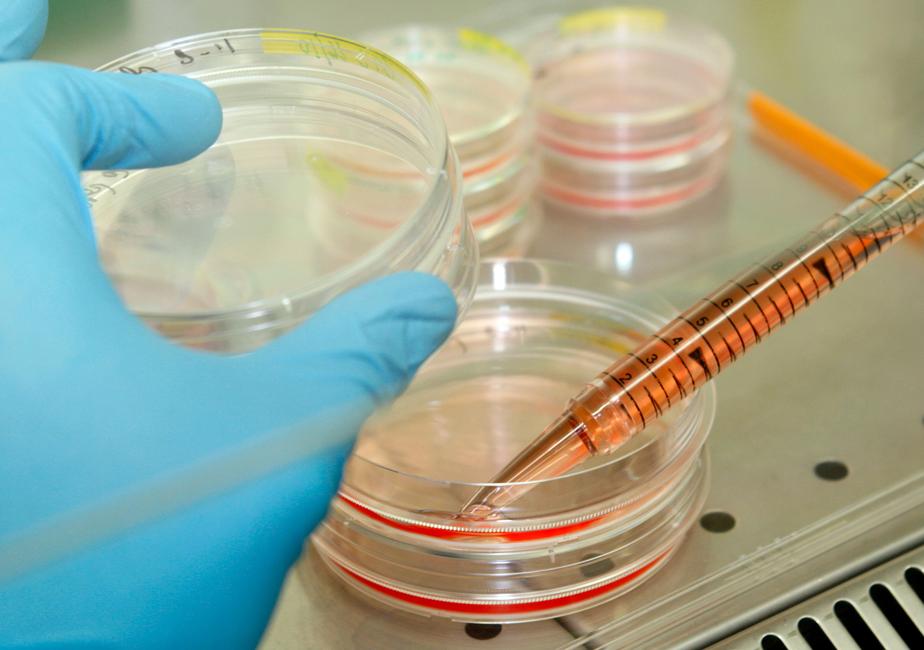
Article cover

©
Recherche sur des cellules souches.
TROMPE-LA-MORT
20 avril 2015
4 technologies prometteuses sur lesquelles travaille la science pour défier la mort
Déjà bien avancées ou en cours d'expérimentation, de nouvelles techniques de médecine régénérative promettent des miracles. De la recellularisation des organes à leur création de toutes pièces par la technologie 3D, notre corps pourrait être bientôt remis à neuf pièce par pièce.
THEMATIQUES
SantéDaniel Hartmann est professeur d’ingénierie appliquée à la santé et de dispositifs médicaux à l’Université C. Bernard-Lyon1, faculté de pharmacie, et membre de l’UMR CNRS 5510. Ses thèmes de recherche principaux portent sur les biomatériaux innovants et l’ingénierie tissulaire.
Populaires
Daniel Hartmann est professeur d’ingénierie appliquée à la santé et de dispositifs médicaux à l’Université C. Bernard-Lyon1, faculté de pharmacie, et membre de l’UMR CNRS 5510. Ses thèmes de recherche principaux portent sur les biomatériaux innovants et l’ingénierie tissulaire.